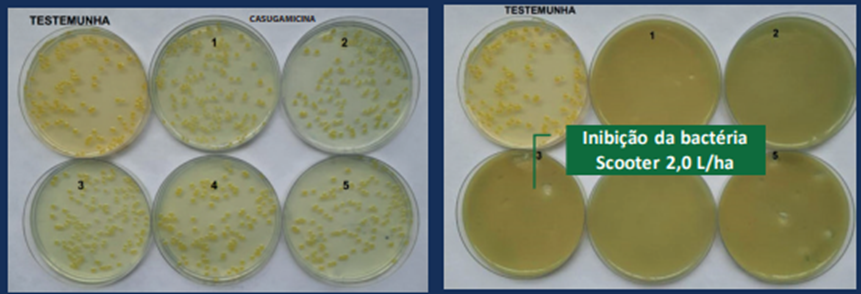

Ao longo de sua trajetória de 33 anos, a Oxiquímica, uma empresa genuinamente brasileira, se destaca pelo compromisso com a inovação e pela criação de tecnologias que impulsionam o desempenho e segurança dos produtos agrícolas.
No âmbito da proteção vegetal, SCOOTER se posiciona como um marco na linha de fungicidas e bactericidas, oferecendo um produto premium no mercado nacional.
Desenvolvido com a tecnologia de oxicloreto de cobre da Oxiquímica combinada com Mancozeb em formulação líquida de alta performance, SCOOTER é reconhecido como referência no setor pela eficácia e confiabilidade que proporciona aos agricultores. Sua presença destaca-se como um dos pilares da excelência da Oxiquímica no campo da proteção de cultivos.
Além da inovação do SCOOTER, a Oxiquímica se destaca pelos mais altos padrões de qualidade e sustentabilidade em todas as etapas de seus processos. A empresa possui as certificações ISO 9001 e ISO 14001, juntamente com a acreditação da ISO 17025, garantindo total confiabilidade e segurança nas análises laboratoriais dos Fungicidas Cúpricos Oxiquímica, alinhados com os mais rigorosos padrões internacionais de qualidade.
Composição SCOOTER
Oxicloreto de cobre Oxiquímica + Mancozeb: a mistura de dois fungicidas protetores (multissítio) é tradicionalmente utilizada pelo produtor por aumentar o espectro de controle de doenças, sendo eficaz para combater fungos, bactérias e oomicetos, como o oídio da videira e a requeima da batata e do tomate.
Com a aceleração nas mudanças climáticas, os patógenos, sejam eles fungos, bactérias ou oomicetos, vêm se adaptando com maior frequência, necessitando de produtos mais potentes para seu controle. SCOOTER traz a inovação necessária para acompanhar esta evolução e elevar os níveis de controle.
Resultados comprovados
Diversas instituições, como o Instituto Biológico, IPACER e Monterra Consultoria testaram e validaram a tecnologia do SCOOTER por meio de estudos exploratórios que visavam analisar a performance do produto em condições de campo e laboratório.
Os estudos foram conduzidos em diferentes regiões produtoras de HF, dando mais segurança e estabilidade aos resultados. Estudos também voltados à área de tecnologia em aplicação foram conduzidos com excelentes resultados, dando ainda mais segurança sobre a aplicabilidade do produto.

Laboratório de Bacteriologia Vegetal (Dra. Susete Destefano)
Conveniência – um único produto com dois fungicidas protetores
- Ação de controle sobre complexo de doenças;
- Facilidade na aplicação (formulação líquida);
- Maior cobertura foliar e menor lavagem pela chuva;
- Com coformulantes de última geração.